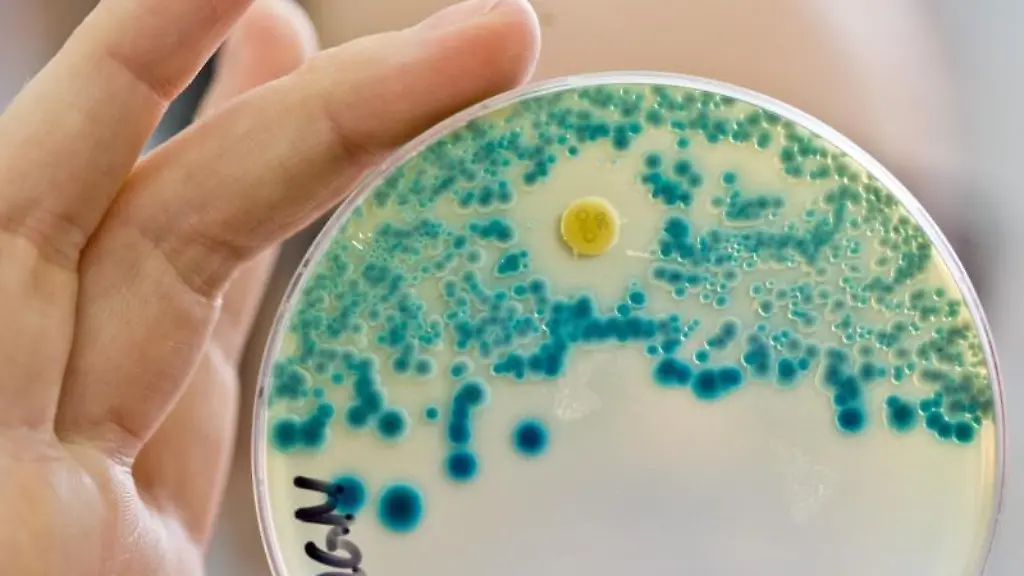
Eine-Indikatorkulturplatte-zum-Nachweis-von-resistenten-Bakterien

Gefahr durch ResistenzenAOK: Zu oft Reserveantibiotika verordnet
Der Anteil von Reserveantibiotika an allen Antibiotikaverordnungen in Deutschland geht zwar seit Jahren zurück, dennoch warnen Forscher angesichts immer noch besorgniserregend hoher Zahlen vor den Folgen des übermäßigen Einsatzes. Der Mensch macht dabei allerdings nicht den größten Anteil aus.
Jedes zweite in Deutschland verordnete Antibiotikum ist ein Reserveantibiotikum, das eigentlich nur eingesetzt werden soll, wenn Standardmedikamente nicht mehr helfen. Im Jahr 2019 entfielen knapp 18 Millionen Verordnungen für gesetzlich Versicherte auf Reserveantibiotika, wie das Wissenschaftliche Institut der AOK (Wido) mitteilte. Jeder sechste Versicherte habe mindestens einmal ein solches Medikament erhalten.
Reserveantibiotika sind eigentlich nur Mittel der zweiten Wahl. Nach den ärztlichen Behandlungsleitlinien sollen sie nicht zur Therapie einfacher Infektionen wie Erkältungen eingesetzt werden, sondern nur im Bedarfsfall bei schweren bakteriellen Erkrankungen, wenn Standardantibiotika wie zum Beispiel Penicilline nicht mehr wirken.
Zwar ist laut der Wido-Analyse der Anteil der Reserveantibiotika an allen Antibiotikaverordnungen seit 2012 rückläufig. Der Anteil lag aber auch 2019 wieder "besorgniserregend hoch", erklärte Helmut Schröder, stellvertretender Wido-Geschäftsführer. Er warnt vor einem sorglosen Einsatz von Reserveantibiotika. "Die einstigen Wunderwaffen gegen Infektionskrankheiten werden durch ihren starken Einsatz sowohl in der Humanmedizin als auch in der Tierhaltung zunehmend stumpfer", so Schröder.
Der übermäßige Einsatz von Antibiotika beim Menschen und in der Tiermast sowie eine unsachgemäße Einnahme der Medikamente, etwa durch falsche Dosierung oder einen vorzeitigen Abbruch der Therapie, fördern Resistenzbildungen gegen Antibiotika. Zum Teil sind Bakterien auch von Natur aus immun gegen bestimmte Antibiotika.
Die ambulanten Verordnungen in der Humanmedizin sind laut Wido "nur die Spitze des Eisbergs". Während im Jahr 2019 rund 339 Tonnen Antibiotika der Versorgung von Patienten in Deutschland dienten, waren es in der heimischen Tierhaltung rund 670 Tonnen. Insgesamt wurden damit 2019 bei Mensch und Tier mehr als 1000 Tonnen Antibiotika eingesetzt, darunter mindestens 376 Tonnen Reserveantibiotika.
Das Problem der Antibiotikaresistenzen werde noch dadurch vergrößert, dass die Pharmaindustrie in den vergangenen Jahren nur wenige neue Antibiotika auf den Markt gebracht habe. "Inzwischen scheint die Politik das Marktversagen in diesem Pharmamarkt zu erkennen und fördert die Forschung und Entwicklung direkt", sagt Schröder. Aktuell fördert die Bundesregierung die Entwicklung neuer Antibiotika bis 2022 mit jährlich zehn Millionen Euro aus dem Haushalt des Bundesforschungsministeriums.